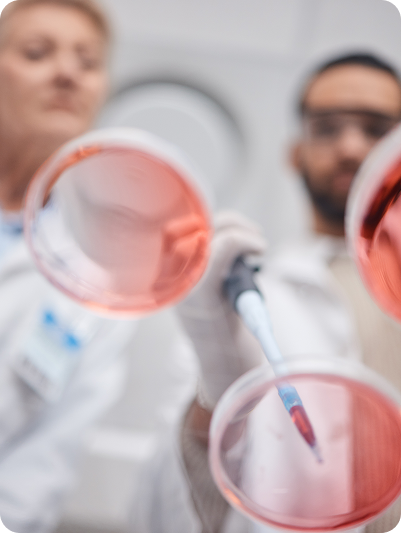

Canada’s Most
Powerful Cancer
Screening Test
Detect cancer earlier through a single blood test. This advanced screening analyzes tumour DNA to identify cancer signals long before symptoms appear, helping individuals and organizations take a proactive approach to health.
- Early Detection
- Expert Assistance
- Ongoing Support

Early Detection
Early Cancer Detection Starts Here
Introducing Canada’s first multi cancer blood test, available now in Western Canada. This simple and highly advanced test detects up to 59 different cancers from a single blood sample. No symptoms required. No long wait times. Only clear answers when you need them most.
This test identifies cancer related DNA fragments in the bloodstream. These fragments act like a molecular fingerprint, often appearing long before symptoms develop or imaging detects abnormalities. The technology is certified laboratory tested in Europe and US, research tested in Canada.
Misconceptions
Common Misconceptions About Cancer
- "Cancer only happens to unhealthy people”.
- “I don’t have a family history of cancer, so I’m not at risk”.
- “I exercise, eat well, and take vitamins—so I’m protected”.
- “Cancer only affects people who don’t take care of their bodies”.
- “I avoid harsh environmental exposures, so I don’t need to worry”.
- “If I had cancer, I would feel it or notice symptoms”.


In reality, cancer can develop in anyone at any age. Many cancers cause no noticeable symptoms in early stages, which is why proactive screening and early detection are essential. Survival rates and quality of life increase drastically with early detection.
Our process
How It Works
01
Book a consultation
Discuss eligibility and next steps directly with Dr. Branden Reid.
02
Provide a blood sample
A quick and simple blood draw performed at our partner clinic, or on site for corporate groups or individuals.
03
Laboratory analysis
Your blood is analyzed for tumour related DNA markers using advanced genomic technology in a specialized lab in Toronto. This test expands screening to more than 74% of cancers responsible for the highest mortality. It is significantly more sensitive than full body imaging because it detects microscopic DNA fragments that cannot be captured on MRI.
04
Results and next steps
If your test is positive, a complimentary private CT scan or MRI is arranged within three weeks, along with urgent referral to oncology if required.


Why Early Detection Matters
“Because Early Answers Could Change Everything”
Cancer is the leading cause of death in Canada, and one in two people will receive a diagnosis in their lifetime. Routine screening tests cover only a small number of cancers. Many high risk cancers, including pancreatic, liver, esophageal, ovarian and stomach cancers, have no established screening programs. More often than not these types of cancers are found inadvertently through scans or late stages when symptoms are apparent. The human body possesses a remarkable ability to disguise illness and maintain function.
This test expands screening to more than 74% of cancers responsible for the highest mortality. It is significantly more sensitive than full body imaging because it detects microscopic DNA fragments that cannot be captured on MRI.
We've got answers
Frequently Asked Questions
We provide clear, straightforward answers to help you understand our cancer screening technology and process.
Research Use Only in Canada. Laboratory Developed Test in the US and Europe!
This type of cancer-detection blood test uses advanced, emerging technology that is still relatively new in the medical field. Because it involves complex laboratory processes and highly specialized equipment, the cost of performing each test remains high.
Public healthcare systems typically adopt new medical technologies only after extensive long-term evaluation, cost-effectiveness studies, and policy review. While this test shows promising potential, it has not yet gone through all the stages required for public funding or coverage.
As the technology continues to advance and becomes more widely adopted, costs may decrease, opening the possibility for broader public healthcare support in the future.
We offer a convenient mobile blood draw service performed by our Registered Nurse. Please contact us directly for mobile pricing details.
We provide blood draws across all major cities in Western Canada. When our team is scheduled to be in your area, we will notify you of the available dates.
For the most up-to-date locations and blood draw schedules, please check our Instagram or Facebook pages or contact us directly.
The test has 88 percent sensitivity and 98 percent specificity. A negative test provides strong reassurance that no cancer DNA was detected.
You will receive a complimentary private CT or MRI within 3 weeks. If imaging confirms cancer, Dr. Reid arranges an urgent referral to the appropriate oncology specialist. You are not left to navigate the system on your own.
Yes. A large study published in Nature Medicine in 2025 evaluated a multi cancer blood test across thousands of participants and reported high accuracy, with approximately 87 percent sensitivity and 98 percent specificity in independent validation. The study also demonstrated strong ability to predict the likely tissue of origin, helping guide follow up care.
No. This test works alongside routine screenings such as mammograms, colon cancer testing (FIT), PAP tests and PSA panel.
Most studies suggest yearly testing, although some patients may be advised to repeat the test every two to three years based on personal risk factors.
Many health spending accounts reimburse the full cost. Coverage varies by provider. Some insurance plans cover private blood work, consult your insurance provider for more details.
Anyone under the age of 25. Individuals diagnosed with cancer within the last five years are also ineligible.
Results typically return within 3 weeks after laboratory processing in Toronto.
Samples are processed at a certified laboratory in Toronto.
No. A negative result does not qualify for a refund. Each test involves significant costs to perform, including advanced laboratory analysis and the expertise of a team of medical professionals. Your fee also covers personalized support and private physician oversight throughout the entire process—not just the outcome of the test.
Every test requires the same level of resources, time, and clinical evaluation, regardless of whether the result is positive or negative.

I feel confident about the future knowing that our family is in capable hands.
Stefan Ball
Warm and supportive environment
Our community fosters friendships and a positive atmosphere where seniors feel valued, safe, and engaged.
Amazing 4.8 rating
The staff treated my mother with kindness and respect. We feel truly cared for here.

Learn More About the Different Cancer Types
Tap the icons to see the 59 types of cancer detectable through our single blood draw technology.

Esophagus
Esophageal Cancer
- Adenocarcinoma
- Squamous Cell Carcinoma
Gastric
Gastric Cancer
- Esophagogastric Junction
- (See Stomach Area for other Gastric Cancers)
Lung
Lung Cancer
- Non-small Cell
- Small Cell
- Neuroendocrine
Pleura
- Mesothelioma
Gastric
Stomach Cancer
- Adenocarcinoma
- Neuroendocrine
Pancreas
Pancreatic Cancer
- Exocrine
- Neuroendocrine
Liver
Liver Cancer
- Hepatocellular Carcinoma
Hepatobiliary
Cholangioicarcinoma
- Distal
- lntrahepatic
- Perihilar
Gallbladder Cancer
Colorectal Cancer
Small Intestine Cancer
- Adenocarcinoma
- Neuroendocrine
Appendix Cancer
- Carcinoma
Colon Cancer
- Adenocarcinoma
- Neuroendocrine
Rectum Cancer
- Adenocarcinoma
- Neuroendocrine
Anal Cancer
- Squamous Cell Carcinoma
- Adenocarcinoma
Testicle
- Testicular Cancer Seminoma
Prostate
- Adenocarcinoma
- Urothelial
Urinary
- Bladder Cancer
- Urethral Cancer

Esophagus
Esophageal Cancer
- Adenocarcinoma
- Squamous Cell Carcinoma
Gastric
Gastric Cancer
- Esophagogastric Junction
- (See Stomach Area for other Gastric Cancers)
Lung
Lung Cancer
- Non-small Cell
- Small Cell
- Neuroendocrine
Pleura
- Mesothelioma
Gastric
Stomach Cancer
- Adenocarcinoma
- Neuroendocrine
Pancreas
Pancreatic Cancer
- Exocrine
- Neuroendocrine
Liver
Liver Cancer
- Hepatocellular Carcinoma
Hepatobiliary
Cholangioicarcinoma
- Distal
- lntrahepatic
- Perihilar
Gallbladder Cancer
Colorectal Cancer
Small Intestine Cancer
- Adenocarcinoma
- Neuroendocrine
Appendix Cancer
- Carcinoma
Colon Cancer
- Adenocarcinoma
- Neuroendocrine
Rectum Cancer
- Adenocarcinoma
- Neuroendocrine
Anal Cancer
- Squamous Cell Carcinoma
- Adenocarcinoma
Cervical Cancer
- HPV 16 and HPV 18
Ovarian Cancer
- Epithelial
- Fallopian Tube Cancer
Endometrial Cancer
- Corpus Uteri
- Carcinoma
- Carcinosarcoma
Urinary System
- Bladder Cancer
- Urinary Cancer
- Urethral Cancer
Breast Cancer
- Invasive Ductal Carcinoma
- Invasive Lobar Carcinoma
- Ductal Carcinoma In Situ
Lymphatic System
Lymphoma
- Non-Hodgkin
- Hodgkin
Hematopoietic System
- Leukemia (ALL, AML, CLL, CML)
- Multiple Myeloma
- Plasma Cell Leukemia
- Solitary Myeloma
- Light Chain Myeloma
Soft Tissue / Sarcomas
- Gastrointestinal Stromal Tumor
- Angiosarcoma
- Dermatofibrosarcoma
- Epitheliod Sarcoma
- Leomyosarcoma
- Liposarcoma
- Myxofibrosarcoma
- Synovial Sarcoma
- Undifferientated
- Pleomorphic
- Sarcoma (UPS)



